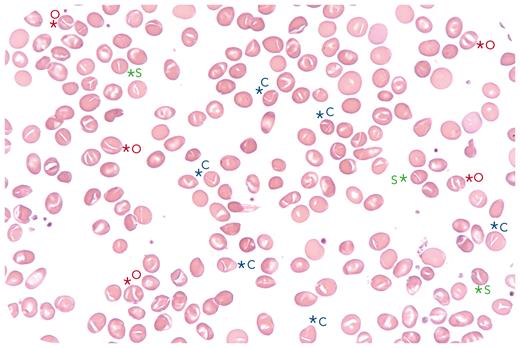
graphic

A 21-year-old Comorian woman was seen for counseling for sickle cell trait. Her mother has symptomatic sickle cell trait. On examination, the patient presented with cutaneous and mucosal jaundice. Laboratory evaluation showed moderate anemia (10.5 g/dL), increased total bilirubin (30 μmol/L), and decreased haptoglobin. The blood smear revealed Melanesian ovalocytes, characteristic of Southeast Asian ovalocytosis (SAO) (original magnification, 63× objective; May-Grünwald-Giemsa stain). Representative cells (o), stomatocytes (s), and other poorly defined red blood cell (RBC) shapes (c) are shown, suggesting the presence of a combination of stomatocytes and ovalocytes with an abnormal hemoglobin distribution. The eosin-5-maleimide binding test was positive with a significant decrease in fluorescence intensity. Molecular analysis revealed the unexpected association of the HBB mutation (HbS trait; rs334) with deletion in SLC4A1 (heterozygous SAO; rs769664228), heterozygous PIEZO1 mutation (xerocytosis; rs200970763), and heterozygous SPTA1 variation (elliptocytosis; rs142775522). Ektacytometry showed only the flat profile, characteristic of SAO.
This case highlights the importance of analyzing the blood smear and molecular data in order to make a precise diagnosis. In our patient’s case, xerocytosis was diagnosed; thus, splenectomy was contraindicated. This is a complex and unique case of 4 genetic RBC diseases: HbS trait, SAO, xerocytosis, and elliptocytosis.
For additional images, visit the ASH Image Bank, a reference and teaching tool that is continually updated with new atlas and case study images. For more information, visit http://imagebank.hematology.org.
This feature is available to Subscribers Only
Sign In or Create an Account Close Modal